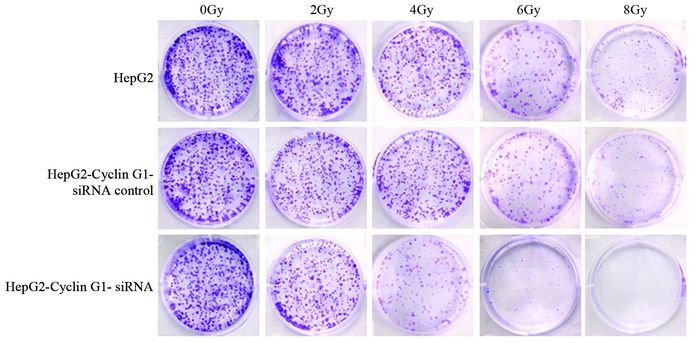

文章信息
- Cyclin G1对肝癌细胞HepG2放射敏感度的影响及其机制
- Effect of Cyclin G1 on Radiosensitivity of Hepatocellular Carcinoma HepG2 Cells and Its Mechanism
- 肿瘤防治研究, 2017, 44(9): 590-595
- Cancer Research on Prevention and Treatment, 2017, 44(9): 590-595
- http://www.zlfzyj.com/CN/10.3971/j.issn.1000-8578.2017.17.0039
- 收稿日期: 2017-02-27
- 修回日期: 2017-05-09
原发性肝癌是一种临床常见的恶性肿瘤,仅有约10%~30%的患者可手术切除[1],且术后易发生复发转移,五年总生存率仅有5%~16%[2],放射治疗是中晚期肝癌的一种有效治疗手段[3-4],但是由于正常肝脏组织的放射耐受性低,肝癌细胞的根治剂量大于其周围正常组织的耐受剂量,常会引起放射性肝损伤,如果能寻找一种有效的放疗增敏剂以提高肝癌细胞的放射敏感度,对于肝癌的放疗将具有重要的意义。
细胞周期蛋白Cyclin G1不仅是一种细胞周期调节蛋白,而且是一种癌基因[5]。Tao等对肝癌全基因组进行细胞群基因分析发现了三种肿瘤驱动基因,而Cyclin G1就是其中之一[6],目前Cyclin G1的生物学功能仍不十分明确,研究显示Cyclin G1在多种肿瘤中均高表达,而且这种高表达可以促进肿瘤细胞生长,它的沉默则可以抑制肿瘤细胞增殖[7-8],这说明了Cyclin G1作为一种致癌基因在肝癌的发生中占有重要地位。但是Cyclin G1是否参与了肝癌放疗敏感度的调节仍不明确,本实验通过成克隆分析研究了Cyclin G1对肝癌细胞HepG2放疗敏感度的影响,并进行了初步的机制研究,现报道如下。
1 材料与方法 1.1 材料人肝癌细胞株HepG2购自中国科学院上海细胞库。RPMI l640培养液及胎牛血清购自美国Gibco公司,0.25%胰酶、磷酸盐缓冲液(PBS)购于美国Hyclone公司,青霉素/链霉素溶液(10 000 u/ml青霉素,10 000 μg/ml链霉素,溶于0.85% NaCl)购于美国Thermo公司。Matrigel胶购于美国BD公司。30%Acrylamide/Bis Solution购于美国Bio-Rad公司,Tris-HCl购于中国Solarbio公司,过硫酸铵(APS)、四甲基乙二胺(TEMED)、SDS-聚丙烯酰胺凝胶(SDS-PAGE)上样缓冲液购于中国Beyoutime公司。Western blot Marker购于美国Thermon公司。pSilencer3.1-H1载体购自美国Invitrogen公司。HIF-1α ELISA试剂盒购于英国Abcam公司,ROS ELISA试剂盒购于美国Neoscientific公司。Bcl-2、Bax及β-actin一抗购于英国Abcam公司。
1.2 方法 1.2.1 细胞培养培养液为RPMI l640培养液,内含10%胎牛血清,100 u/ml青霉素,100 μg/ml链霉素。将HepG2细胞置于37℃、5%CO2培养箱内培养至对数生长期进行实验,2~3天传代一次,0.25%胰酶细胞消化。
1.2.2 X线照射使用医用直线加速器(德国Siemens公司,型号:Oncor),应用6MV X射线进行不同剂量照射,剂量率为300 cGy/min,照射野为20 cm×20 cm,照射时机架角转至180,细胞培养皿下垫2.0 cm厚的剂量补偿板,CT(美国GE公司,型号:High-speed-Dual)下定位,并用Pinnacle 3计算机治疗计划系统(Philips公司)对剂量进行调整。
1.2.3 HepG2-CyclinG1-siRNA细胞系的构建在Cyclin G1 mRNA上寻找符合特征的靶序列(G1/832: 5’-GCA AGA GCT TGT ATC CAA ATG TTT A-3’),合成Cyclin-siRNA序列并形成双链结构;连接于酶切后的pSilencer3.1-H1载体,转化大肠杆菌感受态细胞,挑取阳性克隆、扩增、提取质粒,测序鉴定。将与人的任何基因序列均无同源关系的DNA序列按上述方法构建重组质粒作为阴性对照。按照LipofectamineTM试剂盒说明书进行转染试验。
1.2.4 q-PCR分析HepG2细胞及HepG2-CyclinG1-siRNA细胞常规培养于6孔板中,用TRIzol提取细胞RNA,并反转录成cDNA,β-actin作为内参,在96孔PCR反应板中按说明书依次加入各试剂,制成10 μl的PCR反应体系,反应条件参考试剂盒说明书。每次检测设立3个复孔,至少重复3次。引物由上海生工设计合成。引物序列:Cyclin G1上游引物:5’-AGCTGCAGTCTCTGTCAAG-3’,Cyclin G1下游引物: 5’-ATGTCTCTGTGTCAAAGCCA-3’;β-actin上游引物:5’-AAAGACCTGTACGCCAACAC-3’,β-actin下游引物:5’-GTCATACTCCTGCTTGCTGAT-3’。
1.2.5 成克隆分析取对数生长期细胞,消化离心制成1×104/ml单细胞悬液,按照预实验结果将不同细胞数接种至6孔板中,具体为:0 Gy及2 Gy的照射剂量均接种200个细胞,4 Gy及6 Gy的照射剂量接种400个细胞,8 Gy的照射剂量接种800个细胞。分为HepG2组,HepG2-Cyclin G1-siRNA组及HepG2-Cyclin G1-siRNA对照组。细胞接种后48 h,实验分别接受0、2、4、6、8 Gy的6 MV的X射线照射,继续培养14 d,-20℃冰甲醇固定10 min,0.05%结晶紫在室温下染色30 min后双蒸水小心洗涤3次,空气干燥。倒置显微镜下进行细胞计数,≥50个细胞集落作为1个克隆。实验重复3次,计算克隆形成率(PE)=克隆数/接种细胞数×100%,存活分数=照射各剂量点PE/0GyPE。按多靶单击模型SF=1-(1-e-K*D)N,使用Graphpad 5软件拟合细胞存活曲线,得出K值和N值,计算单独照射组和联合组的SF2、D0和Dq值,并计算放射增敏比(SER)。
1.2.6 ELISA分析实验分为六组:HepG2组,HepG2-Cyclin G1-siRNA对照组,HepG2-Cyclin G1-siRNA组,HepG2+X线照射组,HepG2-Cyclin G1-siRNA对照+X线照射组,HepG2-Cyclin G1-siRNA+X线照射组。细胞接种后48 h,更换培养液,予以8 Gy照射,分别于照射后0、24、48、72 h洗涤细胞培养板,HIF-1α及ROS的测定均参照试剂盒要求,依次加入所需试剂,根据OD值绘制标准曲线,并计算所测样品中HIF-1α及ROS含量。
1.2.7 Western blot分析实验分组同1.2.6。细胞接种后48 h,更换培养液,予以8 Gy照射,照射后48 h提取蛋白,裂解细胞时加入2×loading蛋白上样缓冲液,95℃加热5 min,用10% SDS-PAGE蛋白电泳分离样品,湿转法转至PVDF膜。5%脱脂奶粉室温封闭2 h,加入Bcl-2(1:1 000)、bax(1:1 000)、GAPDH(1:5 000)抗体,4℃孵育过夜,加入辣根过氧化物酶(HRP)标记的二抗室温孵育1 h,ECL化学发光检测显影,在凝胶成像系统上拍照并分析。
1.3 统计学方法采用SPSS 17.0软件进行分析,数据以均数±标准差表示,多组数据间比较用单因素方差分析(one way ANOVA),如果差异有统计学意义,再采用Student-Newman-Keuls法进行两两比较。检验水准α=0.05。
2 结果 2.1 肝癌细胞中Cyclin G1的表达通过q-PCR检测发现,HepG2转染Cyclin G1-siRNA后,其Cyclin G1表达量较HepG2-Cyclin G1-siRNA对照组及HepG2组均明显下降,而HepG2-Cyclin G1-siRNA对照组与HepG2组相比,Cyclin G1的表达量没有明显改变,见图 1。

|
| **: P < 0.001, compared with HepG2 group 图 1 Cyclin G1的相对表达量 Figure 1 Relative expression of Cyclin G1 |
随着放疗剂量的逐渐增加,各组细胞所形成的克隆数逐渐减少,以HepG2-Cyclin G1-siRNA+X线组克隆数下降最为明显,见图 2。根据克隆形成实验的结果,拟合生存曲线见图 3,所得放射生物学参数见表 1,由表 1求得Cyclin G1的相应放射增敏比SERDq为1.41,HepG2-Cyclin G1-siRNA对照组与HepG2组之间差异无统计学意义,说明Cyclin G1对HepG2细胞有放射增敏作用。
|
| 图 2 各组细胞克隆形成情况 Figure 2 Clone forming analysis of HepG2 Cells in each group |

|
| 图 3 HepG2细胞存活曲线 Figure 3 Survival curves of HepG2 cells |
流式细胞分析显示HepG2-Cyclin G1-siRNA细胞中G2/M期细胞比例较HepG2组明显升高,G0/G1期明显下降,而S期改变不明显。2 Gy单次放疗前后细胞比例没有显著改变,见图 4~5。

|
| A: HepG2; B: HepG2+X ray; C: HepG2-Cyclin G1-siRNA; D: HepG2-Cyclin G1-siRNA+X ray 图 4 Cyclin G1对肝癌细胞HepG2细胞周期的影响 Figure 4 Effect of Cyclin G1 on cell cycle of HepG2 cells |

|
| 图 5 Cyclin G1对肝癌细胞细胞周期的影响 Figure 5 Effect of Cyclin G1 on cell cycle of HepG2 cells |
X线照射可引起肝癌HepG2细胞的HIF-1α升高,照射后48 h达到最高,并且与HepG2组相比差异有统计学意义,72 h后,HIF-1α轻度下降,而Cyclin G1-siRNA引起HIF-1α的含量显著下降,见图 6。ROS含量在X射线照射后表现为轻度升高,与照射前相比差异无统计学意义。过表达Cyclin G1-siRNA可以使ROS含量增加,照射后24 h开始升高,48 h后达到高峰,72 h轻度下降,与HepG2组细胞相比具有统计学意义,见图 7。

|
| **: P < 0.001, compared with HepG2 group in each time point 图 6 Cyclin G1及X线照射对肝癌HepG2细胞HIF-1α表达的影响 Figure 6 Effect of Cyclin G1 and X-ray on expression of HIF-1α in HepG2 cells |

|
| **: P < 0.001, compared with HepG2 group in each time point 图 7 CyclinG1及X线照射对肝癌细胞ROS表达的影响 Figure 7 Effect of Cyclin G1 and X-ray on expression of ROS in HepG2 cells |
Western blot结果显示X线照射及Cyclin G1-siRNA均可使Bcl-2表达下降及Bax表达增加,其中以HepG2-Cyclin G1-siRNA联合X线照射组改变最明显,见图 8。

|
| 1: HepG2; 2: HepG2+X ray; 3: HepG2-Cyclin G1-siRNA; 4: HepG2-Cyclin G1-siRNA+X ray; 5: HepG2-Cyclin G1-siRNA control; 6: HepG2-Cyclin G1-siRNA control+X ray 图 8 Cyclin G1及X线对肝癌细胞HepG2凋亡相关蛋白表达的影响 Figure 8 Effect of Cyclin G1 and X-ray on expression of apoptosis-related proteins in HepG2 cells |
放射治疗的生物学基础是粒子辐射通过直接或间接作用引起生物组织的DNA损伤进而杀伤或杀死肿瘤细胞。放疗增敏主要是采用一些化学物质或生物分子以提高放射治疗疗效,目前放疗增敏的主要方向包括改善细胞乏氧以及调控细胞周期,同时细胞再氧合以及细胞周期的再分布也是放射治疗的主要理论基础。Cyclin G1是肝癌癌基因的一种,同时又是细胞周期调控因子,在化疗方面,下调Cyclin G1的表达可以通过细胞周期调节来促进紫杉醇的化疗敏感度。Kimura等研究表明Cyclin G1参与了放疗诱导的细胞周期阻滞(G2/M期阻滞)过程,Cyclin G1基因缺失的小鼠及其胚胎成纤维细胞的放疗敏感度明显增强[9],本研究发现转染Cyclin G1-siRNA后,HepG2细胞表达Cyclin G1明显下降,而下调Cyclin G1的表达可以提高肝癌细胞的放疗敏感度,同时G2/M期细胞比例增加,而G0/G1期细胞比例减少,与文献报道相符。这一结果说明通过下调Cyclin G1的表达诱导的放疗敏感度增高,可能是通过细胞周期调控引起的。
实体瘤乏氧是放射治疗失败的主要原因之一,克服细胞乏氧是改善放疗抵抗及提高放疗疗效的一种有效途径。目前克服乏氧的药物主要包括硝基咪唑类化合物、糖酵解抑制剂以及HIF-1α抑制剂等。其中HIF-1α是近年来研究最多的一种乏氧相关因子,其通过调控血管内皮生长因子的表达参与肿瘤血管生成,并与肝癌的放疗疗效及临床预后相关[10-11]。在放射治疗的研究中发现,HIF-1α在放疗过程中表达较放疗前升高,抑制HIF-1α的表达或活性可以增加肿瘤的放射敏感度[12-14],而本研究显示Cyclin G1-siRNA可以使HIF-1α表达下降,说明Cyclin G1-siRNA增加肝癌细胞放疗敏感度的作用部分是通过下调HIF-1α来实现的。
电离辐射对生物的损伤既有损伤DNA的直接作用,也有辐射产生大量自由基的间接作用,其中电离辐射的间接作用是引起损伤的重要方面[15]。ROS是一类活性氧自由基分子的集合体,生理状况下作为细胞内氧化还原信使,其生成和清除均保持着动态平衡,应激状态下这一平衡状态被打破,并最终引起细胞凋亡,ROS含量越高导致细胞的损伤越大,在放射治疗中,可通过增加ROS含量来提高肿瘤细胞的放疗敏感度[16-17]。本实验发现X线照射后ROS含量轻度升高,与对照组相比差异无统计学意义,而下调Cyclin G1的表达则可使ROS含量明显增加,尤其是合并X线照射后ROS含量增加更为明显,表明Cyclin G1-siRNA对HepG2细胞产生放射增敏效应的机制之一有可能是通过ROS含量的增加而实现的。
大量的研究发现,细胞的放射敏感度与凋亡有关[18-20]。本研究亦进行了相关探索,发现X线辐射可引起Bcl-2表达下降及Bax表达增加,其中Bcl-2为抑制凋亡基因,而Bax为促凋亡基因。说明了X线辐射本身可以诱导HepG2细胞的凋亡,而下调Cyclin G1的表达则可使这一作用加强,说明了Cyclin G1可能通过诱导凋亡来增加肝癌细胞的放射敏感度。
综上所述,通过转染Cyclin G1-siRNA可以增加肝癌细胞系HepG2的放射敏感度,其机制可能与细胞周期调控、HIF-1α调节、ROS含量及凋亡相关蛋白表达有关,但其具体机制以及是否与肝癌患者的放射敏感度相关仍不明确,还需要进一步的研究证实。
| [1] | Lau WY, Lai EC. Hepatocellular carcinoma: current management and recent advances[J]. Hepatobiliary Pancreat Dis Int, 2008, 7(3): 237–57. |
| [2] | Wallace MC, Preen D, Jeffrey GP, et al. The evolving epidemiology hepatocellular carcinoma: a global perspective[J]. Expert Rev Gastroenterol Hepatol, 2015, 9(6): 765–79. |
| [3] | Schlachterman A, Craft WW Jr, Hilgenfeldt E, et al. Current and future treatments for hepatocellular carcinoma[J]. World J Gastroenterol, 2015, 21(28): 8478–91. DOI:10.3748/wjg.v21.i28.8478 |
| [4] | 于金明, 李宝生, 闫婧. 原发性肝癌的放射治疗[J]. 世界华人消化杂志, 2009, 17(10): 1005–7. [ Yu JM, Li BS, Yan J. Radiotherapy primary hepatocellular carcinoma[J]. Shi Jie Hua Ren Xiao Hua Za Zhi, 2009, 17(10): 1005–7. DOI:10.3969/j.issn.1009-3079.2009.10.009 ] |
| [5] | Jensen MR, Factor VM, Fantozzi A, et al. Reduced hepatic tumor incidence in cyclin G1-deficient mice[J]. Hepatology, 2003, 37(4): 862–70. DOI:10.1053/jhep.2003.50137 |
| [6] | Wen W, Han T, Chen C, et al. Cyclin G1 expands liver tumor-initiating cells by Sox2 induction via Akt/mTOR signaling[J]. Mol Cancer Ther, 2013, 12(9): 1796–804. DOI:10.1158/1535-7163.MCT-13-0099 |
| [7] | Baek WK, Kim D, Jung N, et al. Increased expression Cyclin G1 in leiomyoma compared with normal myometrium[J]. Am J Obstet Gynecol, 2003, 188(3): 634–9. DOI:10.1067/mob.2003.140 |
| [8] | Perez R, Wu N, Klipfel AA, et al. A better cell cycle target for gene therapy colorectal cancer: cyclin G[J]. J Gastrointest Surg, 2003, 7(7): 884–9. DOI:10.1007/s11605-003-0034-8 |
| [9] | Tao Y, Ruan J, Yeh SH, et al. Rapid growth a hepatocellular carcinoma and the driving mutations revealed by cell-population genetic analysis whole-genome data[J]. Proc Natl Acad Sci U S A, 2011, 108(29): 12042–7. DOI:10.1073/pnas.1108715108 |
| [10] | 滕凤猛, 吴穷, 陈昌杰. 缺氧诱导因子-1α调控肝癌细胞对奥沙利铂耐药的机制[J]. 肿瘤防治研究, 2014, 41(11): 1176–80. [ Teng FM, WU Q, Cheng CJ. Mechanism hypoxia-inducible factor-1α inducing drug resistance to oxaliplatin in hepatic carcinoma[J]. Zhong Liu Fang Zhi Yan Jiu, 2014, 41(11): 1176–80. DOI:10.3971/j.issn.1000-8578.2014.11.004 ] |
| [11] | Kimura SH, Ikawa M, Ito A, et al. Cyclin G1 is involved in G2/M arrest in response to DNA damage and in growth control after damage recovery[J]. Oncogene, 2001, 20(25): 3290–300. DOI:10.1038/sj.onc.1204270 |
| [12] | Wang B, Ding YM, Fan P, et al. Expression and significance MMP2 and HIF-1α in hepatocellular carcinoma[J]. Oncol Lett, 2014, 8(2): 539–46. |
| [13] | Yang X, Zhu H, Ge Y, et al. Melittin enhances radiosensitivity hypoxic head and neck squamous cell carcinoma by suppressing HIF-1α[J]. Tumour Biol, 2014, 35(10): 10443–8. DOI:10.1007/s13277-014-2218-0 |
| [14] | Zhang YC, Jiang G, Gao H, et al. Influence ionizing radiation on ovarian carcinoma SKOV-3 xenografts in nude mice under hypoxic conditions[J]. Asian Pac J Cancer Prev, 2014, 15(5): 2353–8. DOI:10.7314/APJCP.2014.15.5.2353 |
| [15] | 张珠博, 王小春. 肿瘤细胞辐射敏感度调节新靶点—miRNAs[J]. 肿瘤防治研究, 2013, 40(12): 1193–6. [ Zhang ZB, Wang XC. miRNAs-A new adjustable target for inradiation sensitivity tumor cells[J]. Zhong Liu Fang Zhi Yan Jiu, 2013, 40(12): 1193–6. DOI:10.3971/j.issn.1000-8578.2013.12.020 ] |
| [16] | 吴德华, 朱晓霞, 张洪波, 等. HIF-1α基因表达沉默对肝癌细胞的放射增敏作用[J]. 中国肿瘤临床, 2009, 36(2): 110–3. [ Wu DH, Zhu XX, Zhang HB, et al. Effect Silencing HIF-1α on Radiosensitization in Human Hepatocellular Carcinoma Cell Line[J]. Zhongguo Zhong Liu Lin Chuang, 2009, 36(2): 110–3. ] |
| [17] | Dayal R, Singh A, Pandey A, et al. Reactive oxygen species as mediator tumor radiosensitivity[J]. J Cancer Res Ther, 2014, 10(4): 811–8. DOI:10.4103/0973-1482.146073 |
| [18] | Sun X, Wang Q, Wang Y, et al. Brusatol Enhances the Radiosensitivity A549 Cells by Promoting ROS Production and Enhancing DNA Damage[J]. Int J Mol Sci, 2016, 17(7): pii: E997. DOI:10.3390/ijms17070997 |
| [19] | Liu S, Pan X, Yang Q, et al. MicroRNA-18a enhances the radiosensitivity cervical cancer cells by promoting radiation-induced apoptosis[J]. Oncol Rep, 2015, 33(6): 2853–62. DOI:10.3892/or.2015.3929 |
| [20] | Yang W, Sun T, Cao J, et al. Downregulation miR-210 expression inhibits proliferation, induces apoptosis and enhancesradiosensitivity in hypoxic human hepatoma cells in vitro[J]. Exp Cell Res, 2012, 318(8): 944–54. DOI:10.1016/j.yexcr.2012.02.010 |
 2017, Vol. 44
2017, Vol. 44



